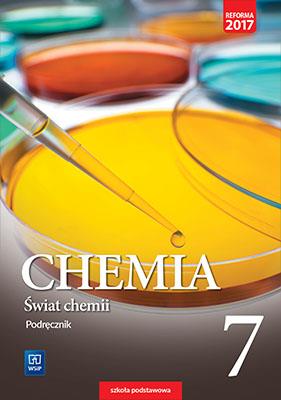
CHEMIA. ŚWIAT CHEMII. PODRĘCZNIK. KLASA 7.

*Ceny mogą ulec zmianie
Szybki podgląd
Cena detaliczna:
29,90 PLN
Oszczędzasz: 60% (17,94 PLN)
Nasza cena:
11,96 PLN
Szybki podgląd
Cena detaliczna:
44,00 PLN
Oszczędzasz: 65% (28,60 PLN)
Nasza cena:
15,40 PLN
Szybki podgląd
Cena detaliczna:
39,00 PLN
Oszczędzasz: 65% (25,35 PLN)
Nasza cena:
13,65 PLN
Szybki podgląd
Cena detaliczna:
39,50 PLN
Oszczędzasz: 65% (25,67 PLN)
Nasza cena:
13,83 PLN
Szybki podgląd
Cena detaliczna:
49,00 PLN
Oszczędzasz: 30% (14,70 PLN)
Nasza cena:
34,30 PLN
Szybki podgląd
Cena detaliczna:
59,00 PLN
Oszczędzasz: 65% (38,35 PLN)
Nasza cena:
20,65 PLN
Szybki podgląd
Cena detaliczna:
40,50 PLN
Oszczędzasz: 65% (26,32 PLN)
Nasza cena:
14,18 PLN
Szybki podgląd
Cena detaliczna:
24,50 PLN
Oszczędzasz: 30% (7,35 PLN)
Nasza cena:
17,15 PLN
Szybki podgląd
Cena detaliczna:
24,50 PLN
Oszczędzasz: 65% (15,92 PLN)
Nasza cena:
8,58 PLN
Szybki podgląd
Cena detaliczna:
22,50 PLN
Oszczędzasz: 65% (14,62 PLN)
Nasza cena:
7,88 PLN
Szybki podgląd
Cena detaliczna:
24,50 PLN
Oszczędzasz: 65% (15,92 PLN)
Nasza cena:
8,58 PLN
Szybki podgląd
Cena detaliczna:
22,50 PLN
Oszczędzasz: 60% (13,50 PLN)
Nasza cena:
9,00 PLN
Szybki podgląd
Cena detaliczna:
48,90 PLN
Oszczędzasz: 30% (14,67 PLN)
Nasza cena:
34,23 PLN
Szybki podgląd
Cena detaliczna:
44,40 PLN
Oszczędzasz: 60% (26,64 PLN)
Nasza cena:
17,76 PLN
Szybki podgląd
Cena detaliczna:
36,00 PLN
Oszczędzasz: 65% (23,40 PLN)
Nasza cena:
12,60 PLN
Szybki podgląd
Cena detaliczna:
41,90 PLN
Oszczędzasz: 65% (27,23 PLN)
Nasza cena:
14,67 PLN
Szybki podgląd
Cena detaliczna:
49,00 PLN
Oszczędzasz: 30% (14,70 PLN)
Nasza cena:
34,30 PLN
Szybki podgląd
Cena detaliczna:
33,00 PLN
Oszczędzasz: 30% (9,90 PLN)
Nasza cena:
23,10 PLN
Szybki podgląd
Cena detaliczna:
48,90 PLN
Oszczędzasz: 65% (31,78 PLN)
Nasza cena:
17,12 PLN
Szybki podgląd
Cena detaliczna:
23,30 PLN
Oszczędzasz: 65% (15,14 PLN)
Nasza cena:
8,16 PLN
Szybki podgląd
Cena detaliczna:
46,67 PLN
Oszczędzasz: 65% (30,34 PLN)
Nasza cena:
16,33 PLN
Szybki podgląd
Cena detaliczna:
45,99 PLN
Oszczędzasz: 65% (29,90 PLN)
Nasza cena:
16,09 PLN
Szybki podgląd
Cena detaliczna:
50,00 PLN
Oszczędzasz: 65% (32,50 PLN)
Nasza cena:
17,50 PLN
Szybki podgląd
Cena detaliczna:
49,99 PLN
Oszczędzasz: 65% (32,49 PLN)
Nasza cena:
17,50 PLN
Szybki podgląd
Cena detaliczna:
19,70 PLN
Oszczędzasz: 65% (12,80 PLN)
Nasza cena:
6,90 PLN
Szybki podgląd
Cena detaliczna:
27,50 PLN
Oszczędzasz: 60% (16,50 PLN)
Nasza cena:
11,00 PLN
Szybki podgląd
Cena detaliczna:
79,00 PLN
Oszczędzasz: 60% (47,40 PLN)
Nasza cena:
31,60 PLN
Szybki podgląd
Cena detaliczna:
39,90 PLN
Oszczędzasz: 65% (25,93 PLN)
Nasza cena:
13,97 PLN
Szybki podgląd
Cena detaliczna:
120,80 PLN
Oszczędzasz: 65% (78,52 PLN)
Nasza cena:
42,28 PLN
Szybki podgląd
Cena detaliczna:
44,90 PLN
Oszczędzasz: 65% (29,18 PLN)
Nasza cena:
15,72 PLN
Szybki podgląd
Cena detaliczna:
46,40 PLN
Oszczędzasz: 65% (30,16 PLN)
Nasza cena:
16,24 PLN
Szybki podgląd
Cena detaliczna:
36,90 PLN
Oszczędzasz: 65% (23,98 PLN)
Nasza cena:
12,92 PLN
Szybki podgląd
Cena detaliczna:
20,00 PLN
Oszczędzasz: 60% (12,00 PLN)
Nasza cena:
8,00 PLN
Szybki podgląd
Cena detaliczna:
24,90 PLN
Oszczędzasz: 65% (16,18 PLN)
Nasza cena:
8,72 PLN
Szybki podgląd
Cena detaliczna:
14,99 PLN
Oszczędzasz: 70% (10,49 PLN)
Nasza cena:
4,50 PLN
Szybki podgląd
Cena detaliczna:
39,00 PLN
Oszczędzasz: 65% (25,35 PLN)
Nasza cena:
13,65 PLN
Szybki podgląd
Cena detaliczna:
59,00 PLN
Oszczędzasz: 65% (38,35 PLN)
Nasza cena:
20,65 PLN
Szybki podgląd
Cena detaliczna:
14,00 PLN
Oszczędzasz: 65% (9,10 PLN)
Nasza cena:
4,90 PLN
Szybki podgląd
Cena detaliczna:
39,30 PLN
Oszczędzasz: 65% (25,50 PLN)
Nasza cena:
13,80 PLN
Szybki podgląd
Cena detaliczna:
25,80 PLN
Oszczędzasz: 65% (16,77 PLN)
Nasza cena:
9,03 PLN
Szybki podgląd
Cena detaliczna:
27,00 PLN
Oszczędzasz: 65% (17,55 PLN)
Nasza cena:
9,45 PLN
Szybki podgląd
Cena detaliczna:
8,20 PLN
Oszczędzasz: 65% (5,33 PLN)
Nasza cena:
2,87 PLN
Szybki podgląd
Cena detaliczna:
29,50 PLN
Oszczędzasz: 65% (19,17 PLN)
Nasza cena:
10,33 PLN
Szybki podgląd
Cena detaliczna:
27,00 PLN
Oszczędzasz: 65% (17,55 PLN)
Nasza cena:
9,45 PLN
Szybki podgląd
Cena detaliczna:
6,99 PLN
Oszczędzasz: 70% (4,89 PLN)
Nasza cena:
2,10 PLN
Szybki podgląd
Cena detaliczna:
30,70 PLN
Oszczędzasz: 65% (19,95 PLN)
Nasza cena:
10,75 PLN
Szybki podgląd
Cena detaliczna:
19,60 PLN
Oszczędzasz: 65% (12,74 PLN)
Nasza cena:
6,86 PLN
Szybki podgląd
Cena detaliczna:
57,00 PLN
Oszczędzasz: 30% (17,10 PLN)
Nasza cena:
39,90 PLN
Szybki podgląd
Cena detaliczna:
61,10 PLN
Oszczędzasz: 65% (39,71 PLN)
Nasza cena:
21,39 PLN
Szybki podgląd
Cena detaliczna:
49,30 PLN
Oszczędzasz: 30% (14,79 PLN)
Nasza cena:
34,51 PLN
Szybki podgląd
Cena detaliczna:
42,70 PLN
Oszczędzasz: 65% (27,75 PLN)
Nasza cena:
14,95 PLN
Szybki podgląd
Cena detaliczna:
55,40 PLN
Oszczędzasz: 65% (36,01 PLN)
Nasza cena:
19,39 PLN
Szybki podgląd
Cena detaliczna:
57,50 PLN
Oszczędzasz: 65% (37,37 PLN)
Nasza cena:
20,13 PLN
Szybki podgląd
Cena detaliczna:
45,00 PLN
Oszczędzasz: 65% (29,25 PLN)
Nasza cena:
15,75 PLN
Szybki podgląd
Cena detaliczna:
51,60 PLN
Oszczędzasz: 65% (33,54 PLN)
Nasza cena:
18,06 PLN
Szybki podgląd
Cena detaliczna:
6,20 PLN
Oszczędzasz: 60% (3,72 PLN)
Nasza cena:
2,48 PLN
Szybki podgląd
Cena detaliczna:
19,99 PLN
Oszczędzasz: 70% (13,99 PLN)
Nasza cena:
6,00 PLN
Szybki podgląd
Cena detaliczna:
79,00 PLN
Oszczędzasz: 70% (55,30 PLN)
Nasza cena:
23,70 PLN
Szybki podgląd
Cena detaliczna:
3,99 PLN
Oszczędzasz: 70% (2,79 PLN)
Nasza cena:
1,20 PLN
Szybki podgląd
Cena detaliczna:
7,90 PLN
Oszczędzasz: 70% (5,53 PLN)
Nasza cena:
2,37 PLN